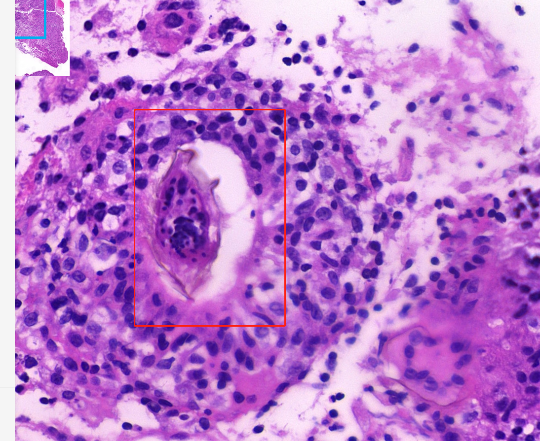
微信图片_20221215163440.png

“脑肿瘤”切下来后是虫卵!
深圳市三医院救治一名脑血吸虫病患者
稿件来源:海角社区
发布时间:2022-12-15 16:35:57
28岁的小谢(化名)头痛1个月,检查后被多家医院怀疑为脑肿瘤,但经开颅手术成功切除“脑肿瘤”后,病理结果却让医生迷惑不解。转诊至海角社区 (南方科技大学第二附属医院)后,在病理科和神经内科的联合诊治下,最终成功揪出了脑子里的真正“凶手”——血吸虫虫卵。
脑部病灶达4-5厘米 “肿瘤”切下来后是虫卵
28岁的小谢头痛1个月后又出现了呕吐,这一次,他终于忍不住去了医院检查,这次检查的头部核磁结果显示,小谢脑部有一个大约4-5厘米的占位性病变,不排除脑肿瘤可能。
“怎么会是脑肿瘤?”此后,小谢辗转了多家医院就诊,但都被告知脑肿瘤的可能性很大。最终,小谢选择接受手术治疗切除了这个“脑肿瘤”。由于占位性病变位于左侧大脑的顶枕叶,而枕叶是人体的视觉中枢,手术后,小谢虽然头痛好转,但是出现了部分视力障碍。
随后有更惊人的消息传来——“脑肿瘤”组织切片的病理报告显示,小谢的“脑肿瘤”实际上是一种脑部寄生虫。
如果不是脑肿瘤,那究竟是什么寄生虫进入人体的脑子里面了?在手术医院的病理科无法确定是哪种脑部寄生虫的情况下,小谢慕名来到了海角社区 院长卢洪洲的门诊,卢洪洲立即判断,所谓的“脑肿瘤”是一种脑寄生虫感染,下一步需要驱虫治疗防止病变进展复发。
在神经内科住院之后,小谢的“脑肿瘤”病理组织切片也被送到深圳市三医院,曾经在北京工作期间遇到过多例脑血吸虫病案例的病理科主任周光德立刻辨认出来,病理组织里都是脑血吸虫卵!
脑血吸虫病非常罕见 是因为接触疫水感染
血吸虫病是一种裂体吸虫,属血吸虫引起的慢性寄生虫病,主要通过皮肤与疫水接触传染,曾经在我国南方农村引起过大规模感染。在积极消灭钉螺这个血吸虫唯一的中间宿主后,我国部分地区的血吸虫疫情基本消失,但如今每年仍有部分地区有散发病例发生。
深圳并非血吸虫的疫区,但小谢曾在3年前接触过湖北地区的湖水,而湖北正是血吸虫病的高发地区。医生推测,小谢接触疫水后,血吸虫尾蚴经小谢皮肤或者黏膜侵入人体,在门静脉系统发育为成虫,成虫在人体肠壁黏膜产卵,部分卵进入大脑的小静脉,然后经过血循环进入脑内,引起脑损害。血吸虫病多累及肝脏、肠道及阑尾等器官,脑部感染比较罕见。
经病理确诊后,小谢的血标本也被送往疾控中心做了寄生虫免疫学检查,结果显示血吸虫抗体阳性。
深圳市三医院神经内科主任赵宇介绍,血吸虫的虫卵寄生在大脑后会引起脑细胞的坏死和炎症反应,炎性渗出物形成肉芽肿侵犯脑组织,如未进行正确及时的驱虫治疗,会导致小谢出现癫痫、偏瘫、失语等严重神经系统症状,甚至危及生命。
小谢在神经内科住院接受规范的驱虫治疗后顺利出院,定期门诊随访复诊,目前情况良好,近期复查头部核磁,病灶已进一步恢复好转。
附件:

粤公网安备 44030702003859号